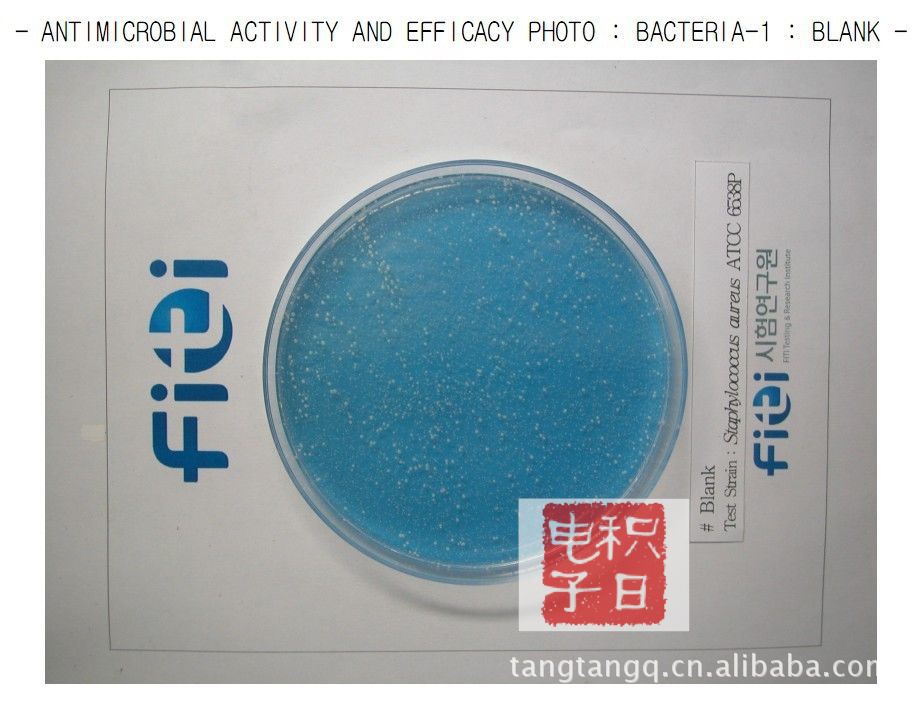

供应抗菌保护膜
硬度:3h
表面有做AG散光处理,具有防眩光功效
相比一般的防刮pet保护膜,本产品在硬化涂层之上又做了Anti Bacterial 抗菌处理,该物质能有效抑制细菌的滋生,以此达到表面抗菌的效果,为普通的贴膜增加了环保卫生的效果。
下面是抗菌测试报告:
1)未使用抗菌的普保护膜材料表面细菌滋生情况。
2)使用具有抗菌功能的保护膜表面细菌滋生情况

上海积日电子有限公司主要从事进口保护膜以及工业胶带的代理及销售,主要有韩国UTC,ADT,DK,三芝、裕屋,日本积水、日东,三樱,美国3M,法国诺凡赛尔,德国宝丽菲姆等著名品牌可为广大客户提供国内外各类型保护膜,可按客户要求的尺寸分切并送货上门。公司仓库面积1300平方米,配有全自动分切机,复卷机,粘着力产品测试仪等设备!
产品型号:
 UTC:UEM-G-8015(网纹) UA-G-005 UA-G-010 UA-G-020 UA-G-040 UA-G-300 UA-B-150 UEV-G-020 UAC-150-300 UA-G-500
UTC:UEM-G-8015(网纹) UA-G-005 UA-G-010 UA-G-020 UA-G-040 UA-G-300 UA-B-150 UEV-G-020 UAC-150-300 UA-G-500
 三芝:低粘:SJ-200、SJ-400A、SJ-465(网纹)、SJ-450、SJ-525 中粘:SJ-530、SJ-580、SJ-610 高粘:SJ-620、SJ-650、SJ-730、SJ-800
三芝:低粘:SJ-200、SJ-400A、SJ-465(网纹)、SJ-450、SJ-525 中粘:SJ-530、SJ-580、SJ-610 高粘:SJ-620、SJ-650、SJ-730、SJ-800
 裕屋:UY-812(网纹)、UY-902、UY-910 UY-930(15C)、UY-920、UY-950
裕屋:UY-812(网纹)、UY-902、UY-910 UY-930(15C)、UY-920、UY-950
 积水:622E、622AX,5760、575、5762、5761、5760B
积水:622E、622AX,5760、575、5762、5761、5760B
 日东:R-100,R-200、SPV-224(蓝色,透明)HR-6030、HR-6020,SPV-367,SPV-225,RP-301,7568
日东:R-100,R-200、SPV-224(蓝色,透明)HR-6030、HR-6020,SPV-367,SPV-225,RP-301,7568
 3M:3K04,331T(蓝色,透明),3K10,5112c,2K04
3M:3K04,331T(蓝色,透明),3K10,5112c,2K04
高透明静电膜:厚度mm:(0.03,0.04,0.05,0.06,0.08 ,0.1)吸附力G(5,12,20)长度M(200,500,1000,2000)
蓝色保护膜: 5g,10g,50g,80g,100g,150g,200g,300g粘度
高粘保护膜:5c(300g,400g,500g,600g,800g,900g)8c(400g,600g)15c(500g,600g)
15C厚保护膜:50g,100g,200g,300g,400g,500g,600g粘度
PET保护膜:厚度C(5.6,7.5,10,12.5) 粘度(低粘,中粘)胶型(亚克力胶,硅胶,静电自吸附)层数:(单层,双层,三层)特性(普通,抗刮,防眩)
工业胶带:3M,日东,SONY,积水,寺岗,宝友以及各种耐高温胶带。
欢迎来电咨询洽谈,索样!

